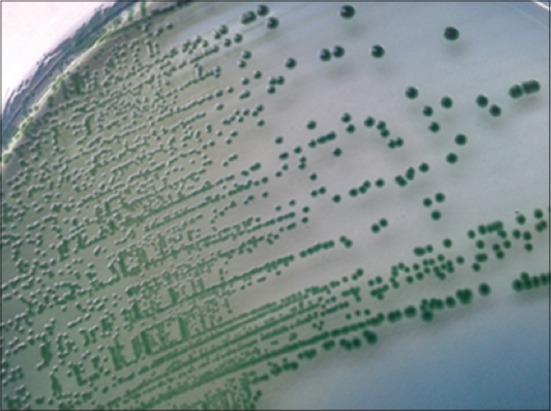
https://cdn.ncbi.nlm.nih.gov/pmc/blobs/4f10/4774662/3109a8d5e1e5/VetWorld-8-1237-g001.jpg

一项关于气单胞菌属及其肠毒素基因在井水、自来水和瓶装水样本中的流行情况的研究。
A study on the prevalence of Aeromonas spp. and its enterotoxin genes in samples of well water, tap water, and bottled water.
作者信息
Didugu Hareesh, Thirtham Madhavarao, Nelapati Krishnaiah, Reddy K Kondal, Kumbhar Baba Saheb, Poluru Anusha, Pothanaboyina Guruvishnu
机构信息
Animal Disease Diagnostic Laboratory, Vijayawada, Andhra Pradesh, India.
Department of Veterinary Public Health and Epidemiology, College of Veterinary Science, Proddatur, Andhra Pradesh, India.
出版信息
Vet World. 2015 Oct;8(10):1237-42. doi: 10.14202/vetworld.2015.1237-1242. Epub 2015 Oct 28.
AIM
The aim of this work was to study the prevalence of Aeromonas spp. and its enterotoxin genes in various water sources.
MATERIALS AND METHODS
125 samples (50 from well water, 50 from tap water, and 25 from bottled water) were collected from various sources in and around Greater Hyderabad Municipal Corporation and examined for the presence of aeromonads by both cultural and polymerase chain reaction (PCR) assay. Alkaline peptone water with ampicillin was used as enrichment. Aeromonas isolation medium and ampicillin dextrin agar were used as selective media. The boiling and snap chilling method was used for DNA extraction. Primers targeted against 16S rRNA, aer, and ast were used to identify aeromonads and its enterotoxins.
RESULTS
48%, 18%, and 12% of well water, tap water, and bottled water samples were found positive by cultural assay with an overall prevalence of 28.8%. Aeromonads were detected in 32 % (52% in well water, 20% in tap water, and 16% in bottled water) of samples by PCR assay. Aerolysin (aer) gene was noticed in 34.6%, 20%, and 0% of well water, tap water, and bottled water samples, respectively, with an overall prevalence of 27.5%. Thermostable cytotonic enterotoxin (ast) was observed in 37.5% (42.3% in well water, 30% in tap water, and 25% in bottled mineral water) of samples.
CONCLUSIONS
Presence of aeromonads and its toxin genes in various sources of water is of public health concern and emphasizes the need for necessary preventive measures to tackle the problem.
目的
本研究旨在调查不同水源中气单胞菌属及其肠毒素基因的流行情况。
材料与方法
从大哈里亚纳市政公司及其周边地区的不同水源采集了125份水样(50份来自井水,50份来自自来水,25份来自瓶装水),通过培养和聚合酶链反应(PCR)检测气单胞菌的存在。含氨苄青霉素的碱性蛋白胨水用作增菌培养基。气单胞菌分离培养基和氨苄青霉素糊精琼脂用作选择性培养基。采用煮沸和速冻法提取DNA。使用针对16S rRNA、aer和ast的引物来鉴定气单胞菌及其肠毒素。
结果
培养法检测发现,井水、自来水和瓶装水样本的阳性率分别为48%、18%和12%,总体阳性率为28.8%。PCR检测发现,32%的样本中气单胞菌呈阳性(井水为52%,自来水为20%,瓶装水为16%)。气溶素(aer)基因在井水、自来水和瓶装水样本中的检出率分别为34.6%、20%和0%,总体检出率为27.5%。耐热细胞毒素(ast)在37.5%的样本中被检测到(井水中为42.3%,自来水中为30%,瓶装矿泉水中为25%)。
结论
不同水源中气单胞菌及其毒素基因的存在对公众健康构成威胁,强调需要采取必要的预防措施来解决这一问题。